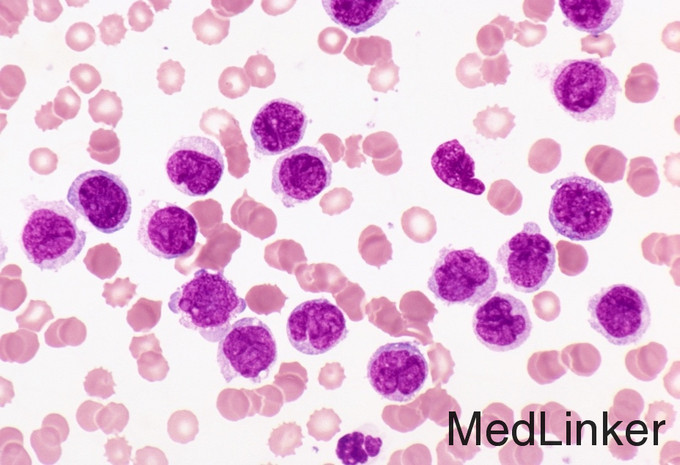

AML-M5b一例
主诉 病史
男,35岁 因“确诊急性髓系白血病4月余”入院。 现病史:患者5月余前因呕吐在当地医院检查发现血常规异常(具体数据不详),未予以重视。2015年2月4日来我院门诊复查血象示白细胞及血小板减少(WBC 1.9G/L,Hb 150g/L,Plt 50G/L),因身体不适未做骨穿。随后于2015年4月在当地医院住院后查血常规示全血细胞减少(WBC 1.01G/L,Hb 101g/L,Plt 36G/L,2015年4月23日),并行骨穿检查,诊断考虑AML-M5b,未行特殊治疗。2015-5-2来我科诊治,诊断为AML-M2,给予化疗:于2015/5/7至5/13给予IA方案化疗(IDA 总剂量50mg,20mgqd(2015.5.7-2015.5.8),10mg 2015.5.9,Ara-C 0.1g,q12h,d1-d7),好转后出院;2015-6-12我科:阿糖胞苷(4.0g,q12h,6月16日、18日及20日);2015-08-02按计划化疗阿糖胞苷4g,q12h(8月2日、4日及6日),化疗过程中监测患者体温、血象、CRP变化,预防抗真菌感染治疗,患者病情好转后出院。2015-09-16行阿糖胞苷4g,q12h(9月16日-9月18日)及依托泊甙(0.2g/d,9月19日及20日)化疗动员,化疗过程中监测患者体温、血象、CRP变化,预防抗真菌治疗,粒缺恢复期间给予外周血干细胞采集两次。今为行自体造血干细胞移植,门诊以“急性髓系白血病”收入。 起病以来,患者精神、睡眠尚可,饮食一般,二便如常,体力、体重无明显变化。
查体 辅查
生命体征平稳,心肺腹体检未见明显异常。 专科情况:皮肤巩膜无黄染,全身皮肤黏膜未见出血点、紫癜和瘀斑,浅表淋巴结未触及肿大,胸骨无压痛,心肺听诊无明显异常,腹平软,无压痛及反跳痛,肝脾肋下未触及,双下肢无凹陷性水肿。 骨穿病理如下。

诊断 处理
诊断:AML-M5b 治疗:准备行自体干细胞移植。

随访 讨论
目前对于AML-M5b的治疗尚无有效方法,平均缓解率60%,一旦复发疗效更差,自体造血干细胞移植无排斥反应,但复发率较高,因此对于AML患者,期待更有效的疗法。
